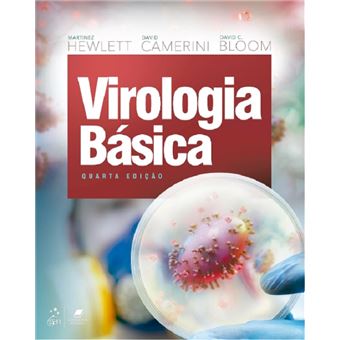
Virologia básica - 1

Virologia básica
Martinez Hewlett , David Camerini, David C. Bloom
Estado :
Novo
Vendido por
País de expedição : Portugal Continental
Ofertas neste produto
-
OPORTUNIDADE PORTES GRÁTISPortes Grátis neste artigo. Oferta válida até - limitada ao stock existente e aplicável nos artigos vendidos e expedidos por WLR STORE LDA.
Resumo
Ver tudo
O campo da virologia tem mudado em um ritmo surpreendente,com o surgimento de novas doenças e, junto delas, técnicas cada vez mais sofisticadas para estudá-las e tratá-las. Por isso, foi necessário e importante atualizar esta obra, referência mundial no ensino dessa disciplina. Mantendo o estilo das edições anteriores, os capítulos são de fácil leitura, bem ilustrados e apresentam noções básicas de virologia,técnicas virológicas, biologia molecular e patogênese da doença viral humana. Além disso, esta quarta edição traz...
Outras ofertas

Virologia básica
Resumo
O campo da virologia tem mudado em um ritmo surpreendente,com o surgimento de novas doenças e, junto delas, técnicas cada vez mais sofisticadas para estudá-las e tratá-las. Por isso, foi necessário e importante atualizar esta obra, referência mundial no ensino dessa disciplina. Mantendo o estilo das edições anteriores, os capítulos são de fácil leitura, bem ilustrados e apresentam noções básicas de virologia,técnicas virológicas, biologia molecular e patogênese da doença viral humana. Além disso, esta quarta edição traz novas informações sobre os vírus Ebola, influenza, HIV, da hepatite C e os coronavírus,e ainda apresenta as mais recentes técnicas virológicas e os avanços em terapias virais.
Publicidade
Avaliações dos nossos clientes
Virologia básica
Sê o primeiro a dar
a tua opinião sobre este produto
Características
- Editora
-
Guanabara Koogan
- Idiomas
-
Português Brasil
- Número de páginas
-
432
- Encadernação
-
Capa Mole / Paperback
- Altura
-
28x21
- Data de lançamento
-
21/07/2023
- EAN
-
9788527739597
Publicidade
Publicidade